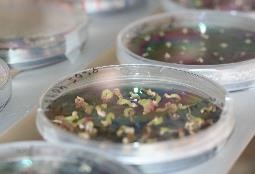
Image

Nachweis latenter Allorhizobium vitis (Mauke) Infektionen
Arbeitsgruppe
Rebenbiotechnologie

Embryogene Rebenzellen in Flüssigkultur
Zwei Drittel des Produktionswertes der Landwirtschaft in Rheinland-Pfalz werden durch Sonderkulturen erbracht, v.a. durch den Weinbau, der über 60 % der Deutschen Weinbaufläche ausmacht.
Die Arbeitsgruppe "Rebenbiotechnologie" will die Wettbewerbs- und Zukunftsfähigkeit der Weinwirtschaft in Rheinland-Pfalz durch Forschungsprojekte und spezifische Dienstleistungen im Bereich des Weinbaus unterstützen. Die Anwendung molekularbiologischer und biotechnologischer Methoden und der in vitro-Kultur bilden hierbei die Basis zur Entwicklung neuer Problemlösungsansätze für die Bekämpfung von Rebkrankheiten.
Transformation von Reben zur funktionellen Genanalyse
Markergen-Eliminierung
Viruseliminierung
Identifizierung und Unterscheidung von Reben-Unterlagssorten
VITIFUTUR (Interreg V)
Siliziumdioxid-Nanoschichten und
eingebettete Verbindungen zum Schutz
vor Sonne und Pilzen in Obst- und Weinbau

Rebenembryonen grünfluoreszierendes
Protein (GFP) exprimierend
Protein (GFP) exprimierend
Konversion transformierter Regenerate

Regenerate aus einem
Transformationsexperiment
Transformationsexperiment
Ansprechpartner
Gabi Krczal
Telefon: 06321 / 671 1301
